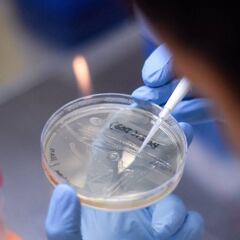
El coronavirus se podría transmitir hasta 90 días después de la infección

Muertes en España por coronavirus: datos de la curva epidemiológica, hoy, 16 de septiembre
Te informamos de la última hora de los datos de la COVID-19 en España, por comunidades autónomas y la evolución de la curva epidemiológica hoy, 16 de septiembre.

Sanidad ha publicado este miércoles los datos acerca de la evolución de la pandemia que, a causa de los nuevos brotes, continúa sumando contagios en línea ascendente. El coronavirus está siendo el principal protagonista del año 2020. Desde su aparición en China, en noviembre de 2019, ha mostrado su alta tasa de contagios y llegó hace algo más de cuatro meses a Europa, siendo Rusia, Reino Unido y España los tres países más afectados por un virus altamente contagioso y que ha pasado de epidemia a pandemia según ha reconocido la OMS.
El dato de muertes con fecha de defunción en los últimos siete días es de 366, mientras que la cifra total de decesos es de 30.243, 239 más que el martes. En cuanto a los positivos por PCR, este miércoles se han añadido 11.193 contagios a la serie histórica, de los cuales 4.728 se han fechado en las últimas 24 horas. En total son 614.360 infectados en España.
Madrid vuelve a ser la comunidad con más nuevos positivos notificados en las últimas 24 horas, 1.854, por delante de País Vasco, con 429, mientras que Aragón suma 291, Andalucía 327 y Cataluña 214. Los datos en España continúan en línea ascendente, siguen surgiendo brotes por todo el país y los contagios podrían volver a descontrolarse.
📢Actualización de datos de #COVID19 en Españahttps://t.co/gBIj1j5Unx
— Ministerio de Sanidad (@sanidadgob) September 16, 2020
➡️Materiales de información sobre el #coronavirus
https://t.co/3JRZJojRhC pic.twitter.com/qYw3VKZT29
¿Qué es el pico de contagios?
Es uno de los conceptos claves y las frases más repetidas a lo largo de estos días. Cuando se alcance el pico de contagios, las labores para acabar con el virus se intensificarán y se verá esa luz al final del túnel. Uno de los aspectos positivos es que España tiene como referencias a China e Italia, los dos países que sufrieron el golpe del COVID-19 antes.
El primer caso de coronavirus en el mundo data del 17 de noviembre de 2019 y fue un hombre de 55 años residente en Wuhan (Hubei), el paciente cero. Desde esa fecha, China tardó 116 días en llegar al pico. Un pico que alcanzó el 12 de marzo, es decir, casi cuatro meses después. Estados Unidos es el país con mayor número de contagiados y fallecidos del mundo. Cuenta ya con más de 6,7 millones de casos y más de 200.000 decesos. India, con más de 5 millones de contagiados, es el segundo país con más infectados, a lo que añaden más de 82.000 muertes. Brasil, por su parte, es el tercer país con más contagios del mundo, con más de 4,3 millones de positivos. Además, suma más de 132.000 fallecidos.
¿Qué es la curva epidemiológica?
Sin duda alguna, este es otro de los conceptos claves de la enfermedad. La curva epidemiológica es una representación gráfica que da información sobre el patrón de la pandemia y a través de ella se puede observar su evolución. Mide el número de casos (en este caso del coronavirus) durante un número determinado de tiempo.
Fernando Simón, director del Centro de Coordinación de Alertas y Emergencias Sanitarias, lo explicó de una manera didáctica: "Cuando tenemos una epidemia esperamos a que empiecen los casos y vayan afectando, progresivamente, a la población. Cuando la masa crítica de población desaparece, esperamos que vaya bajando esa curva. El objetivo de la detección precoz es actuar al inicio para evitar que la curva siga un patrón en el que los casos no aumentan tanto y se alcance pronto el pico para poder eliminar gran parte de la epidemia".
Noticias relacionadas
En realidad, tanto el pico de contagios como la curva epidemiológica están directamente relacionados. El objetivo es que la línea de esa curva no sea tan vertical, sino que tienda hacia una montaña plana. Cuando esa curva vea invertida su tendencia, después de marcar su pico más alto, es cuando se habrá alcanzado el pico de contagios. A partir de ahí, el número de contagios cada día debería empezar a descender día tras día.
Aunque actualmente, el coronavirus está avanzando en España con una curva muy similar a la de principios de marzo. Concretamente, a la semana del 5 al 11 de dicho mes, poco antes de que se decretara el estado de alarma. La gran diferencia radica en que se están detectando mejor y más rápido los nuevos casos, lo que permite a las autoridades actuar más pronto.
Casos en las comunidades autónomas de España
La comunidad autónoma más afectada vuelve a ser Madrid, donde ya hay más contagios confirmados por PCR (178.118) que en Cataluña (126.234). Madrid es también la comunidad que registra más fallecidos (8.955). Cataluña, por su parte, contabiliza un total de 5.787 muertes. Siguen a estas regiones Andalucía (44.607 positivos y 1.631 decesos), País Vasco (38.324 y 1.745), Castilla y León (37.123 y 2.920), y Comunidad Valenciana (33.150 y 1.531), van por detrás de todas estas, pero suman casos a una velocidad similar.